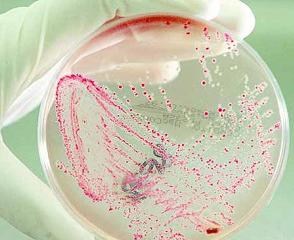

Кишечная палочка (Escherichia coli) — распространенный микроорганизм в кишечнике человека и животных. Большинство штаммов безвредны и полезны для пищеварения, но некоторые могут вызывать серьезные заболевания. В статье рассмотрим симптомы инфекций, вызванных патогенными штаммами, а также методы диагностики и лечения. Знание этих аспектов поможет читателям распознать опасные признаки и обратиться за медицинской помощью, что важно для предотвращения осложнений и поддержания здоровья.
Общая характеристика
Откуда берется кишечная палочка и что это за микроорганизм? Эшерихия, или кишечная палочка, представляет собой основную аэробную флору человеческого кишечника. Она была названа в честь педиатра Теодора Эшериха, который впервые выделил этот микроорганизм из кишечника ребенка. Внешний вид палочек – прямые с закругленными концами. При микроскопическом исследовании можно наблюдать как отдельные клетки, так и их пары.
Оптимальная температура для роста кишечной палочки составляет 37 градусов Цельсия. В процессе брожения ферменты расщепляют углеводы, образуя кислоты или газы. Эти микроорганизмы хорошо развиваются на простых питательных средах и могут вызывать различные заболевания, известные как эшерихиозы.
Некоторые люди испытывают беспокойство из-за наличия кишечной палочки в организме. Однако стоит отметить, что E. coli играет важную роль в защите от патогенных бактерий, попадающих в желудочно-кишечный тракт, а также активно участвует в обменных процессах и способствует укреплению иммунной системы.
Микробные сообщества в организме обладают способностью к саморегуляции, поддерживая экологическое равновесие. Неблагоприятные факторы могут вызвать изменения в составе и количестве микрофлоры, что приводит к нарушению этого равновесия.
В результате таких изменений могут возникать более агрессивные штаммы E. coli, способные вызывать инфекционные заболевания – эшерихиозы:
- энтерит (воспаление тонкой кишки);
- колит (воспаление толстой кишки);
- секреторная диарея;
- геморрагическая диарея, вызванная поражением слизистых оболочек ЖКТ энтеротоксинами;
- воспаление брюшины;
- заболевания уретры;
- легочные инфекции;
- воспалительные процессы в спинномозговой оболочке.
Врачи подчеркивают, что кишечная палочка, особенно её патогенные штаммы, может вызывать широкий спектр симптомов, включая диарею, боли в животе, тошноту и рвоту. Важно осознавать, что проявления инфекции могут варьироваться от легких до тяжелых, в зависимости от штамма и состояния здоровья пациента. Специалисты акцентируют внимание на необходимости своевременной диагностики, так как некоторые штаммы могут привести к серьезным осложнениям, таким как гемолитико-уремический синдром. Лечение обычно включает поддерживающую терапию, такую как регидратация и соблюдение диеты. В некоторых случаях может потребоваться применение антибиотиков, однако их использование должно быть строго обосновано, чтобы избежать ухудшения состояния. Врачи рекомендуют соблюдать меры предосторожности, включая тщательную термическую обработку пищи и соблюдение гигиенических норм, чтобы снизить риск заражения.
Эксперты в области медицины подчеркивают, что кишечная палочка, особенно её патогенные штаммы, может вызывать разнообразные симптомы, включая диарею, боли в животе, тошноту и рвоту. Важно отметить, что проявления инфекции могут варьироваться от легких до тяжелых, в зависимости от штамма и состояния здоровья пациента. В случае появления таких симптомов, специалисты рекомендуют немедленно обратиться к врачу для диагностики и назначения адекватного лечения. Обычно терапия включает поддерживающую терапию, такую как регидратация, а в некоторых случаях могут потребоваться антибиотики. Профилактика также играет ключевую роль: соблюдение правил гигиены и тщательная термическая обработка пищи могут значительно снизить риск заражения.

Этиологический фактор
Основной причиной инфицирования является нарушение гигиенических норм.
Существует два вида передачи инфекции:
- 1) Водный вид основан на внедрении коли инфекции в организм, посредством употребления не качественной или не кипяченой воды;
- 2) Алиментарный путь передачи инфекции обусловлен приемом обсемененной пищи.
Не редки случаи пищевых отравлений. В результате проникновения в ЖКТ не только агрессивного штамма эшерихии, но и продуктов ее жизнедеятельности, вырабатывающих органические кислоты. Продукты, обсемененные токсинами, являются ядом для организма.
В пользу этиологического фактора нарушения гигиены говорит и тот факт, что у женщин при взятии мазка из выгины часто обнаруживается палочковидная кишечная бактерия и диагностируется бактериальный вагиноз. Появляются вагинальные выделения темного цвета со специфическим запахом .
Прямой путь к развитию кандидоза. Причина:
- грязное нижнее белье;
- не правильная гигиена половых органов;
- пользование некачественной туалетной бумагой.
По этой же причине происходят частые проявления уретральных воспалительных процессов у женщин – следствие присутствия в мочевыводящих путях, и соответственно в урине палочки E. Coli.
Локализация эшерихии в полости мочевика вызывает:
- сильный воспалительный процесс;
- повреждение верхнего эпителиального слоя;
- проявление сильных болей и жжения;
- частые позывы к мочеиспусканию.
| Симптом | Тяжесть | Лечение |
|---|---|---|
| Диарея (водянистая или слизистая) | Легкая – Тяжелая | Регидратация (пероральная или внутривенная), диета BRAT (бананы, рис, яблочное пюре, тосты), пробиотики (в некоторых случаях) |
| Спазмы в животе | Легкая – Умеренная | Тепло, отдых, спазмолитики (по назначению врача) |
| Тошнота и рвота | Легкая – Умеренная | Отказ от пищи на некоторое время, регидратация, противорвотные препараты (по назначению врача) |
| Лихорадка | Легкая – Тяжелая | Жаропонижающие препараты (парацетамол), обильное питье |
| Кровь в кале | Умеренная – Тяжелая | Немедленная медицинская помощь, антибиотики (по назначению врача) |
| Обезвоживание | Легкая – Тяжелая | Регидратация (пероральная или внутривенная), электролиты |
| Боль в животе | Легкая – Тяжелая | Тепло, отдых, спазмолитики (по назначению врача), в тяжелых случаях – операция |
Интересные факты
Вот несколько интересных фактов о кишечной палочке, ее симптомах и лечении:
-
Разнообразие штаммов: Кишечная палочка (Escherichia coli) включает более 700 различных штаммов, из которых лишь некоторые могут вызывать заболевания у человека. Например, штамм E. coli O157:H7 известен своей способностью вызывать тяжелые пищевые отравления, сопровождающиеся симптомами, такими как диарея, боли в животе и иногда гемолитико-уремический синдром.
-
Симптомы и инкубационный период: Симптомы инфекции, вызванной патогенными штаммами кишечной палочки, могут проявляться через 1-10 дней после заражения, в зависимости от штамма. Основные симптомы включают диарею (иногда с кровью), спазмы в животе, тошноту и рвоту. Важно отметить, что у некоторых людей инфекция может протекать бессимптомно.
-
Лечение и профилактика: Лечение кишечной палочки в большинстве случаев симптоматическое, включая поддержание водного баланса и, при необходимости, применение противодиарейных средств. Антибиотики не всегда рекомендуются, так как они могут усугубить состояние при некоторых штаммах. Профилактика включает соблюдение правил гигиены, тщательное мытье рук и правильное приготовление пищи, чтобы избежать заражения.

Симптомы кишечной палочки
Латентный период заражения может продолжаться до семи дней. В течение этого времени первые признаки инфекции, вызванной кишечной палочкой, могут не проявляться.
Затем появляются следующие симптомы:
- расстройства пищеварения, проявляющиеся в виде сильной диареи;
- рвота зеленого оттенка;
- повышение температуры и лихорадка;
- периодическая тошнота и общая слабость;
- снижение аппетита;
- тянущие боли в области живота.
В результате естественной очистки кишечника клинические проявления могут исчезнуть через несколько дней. Инфекция у взрослых, вызванная E. coli, обычно не требует срочного медицинского вмешательства. Однако детям, у которых есть подозрение на инфекцию, необходимо срочно обратиться за медицинской помощью, так как наличие эшерихий у детей может быть крайне опасным.
Также читайте о симптомах и лечении кишечной инфекции у мужчин и женщин.
Кишечная палочка, или Escherichia coli, является естественным компонентом микрофлоры человека, но некоторые её штаммы способны вызывать серьезные заболевания. Люди часто сталкиваются с такими симптомами, как диарея, боли в животе, тошнота и иногда высокая температура. Эти проявления могут быть связаны с пищевыми отравлениями или инфекциями, вызванными употреблением загрязненной пищи или воды. Важно помнить, что подход к лечению зависит от степени тяжести состояния. В большинстве случаев достаточно поддерживающей терапии, включая обильное питье и отдых. Однако в более серьезных случаях может потребоваться назначение антибиотиков. Профилактика остается важнейшим аспектом: соблюдение гигиенических норм и тщательная термическая обработка продуктов питания помогают избежать заражения.
Разновидности кишечной палочки
Механизм действия кишечной бактерии зависит от определенного штамма коли-инфекции. Одни могут находиться в организме без последствий, другие, более агрессивные, вызывают острую или хроническую форму диареи.
Кишечную инфекцию вызывают пять видов E. Coli:
- 1) Энтеротоксигенная кишечная палочка – следствие выделения энтеротоксинов большим количеством бактерий, прилипших ворсинками к эпителию в нижнем отделе тонкой кишки. Образуют обширные колонии. Образование низкомолекулярного термостабильного токсина способствует выделению в просвет кишки биологической жидкости, выделяемой клетками.
Проявляется рвотой, гастроэнтеритом и секреторной диареей. - 2) E. Coli энтеропатогенного вида – данный вид служит наиболее вероятной причиной гастроэнтерита у детей. Попадая в верхний слой слизистой тонкого кишечника, бактерия разрушает ее эпителий и ворсинки кишечника, нарушая процессы всасывания воды и питательных ферментов. Проявляется тяжелой формой кишечного расстройства, длительностью более двух недель.
- 3) Энтероинвазивный вид -(Shigella). Характеризуется обильной водянистой диареей, кишечными болями и кровавым стулом. Вследствие проникновения, размножения и разрушения клеток эпителия кишечника. У детей нарушает электролитный баланс, что грозит развитием обезвоживания.
- 4) Гемолитический вид коли инфекции – наиболее серьезный вид инфекции, вызывающий угнетение двигательных функций желудка и кишечника, вплоть до паралича гладких мышц этих органов. Быстро разрушает слизистый слой толстого кишечника, вызывая понос с кровью (колит и геморрагический колит)
- 5) Энтерогеморрогический вид эшерихии – имеет способность быстрого проникновения в эпителиальные клетки, вызывает их гибель, провоцируя геморрогический колит и почечные патологии.

Уретральные инфекции
Образование инфекций, вызванных уропатогенными кишечными палочками, связано с состоянием кишечной микрофлоры. Когда бактерии проникают в уретру, а затем в мочевой пузырь, они активно размножаются на переходной части эпителия. Это происходит под воздействием различных анатомических или физиологических аномалий, которые мешают нормальному оттоку мочи.
Среди детей младше одного года чаще всего заболеванию подвержены мальчики, тогда как в период полового созревания – девочки. У девушек развитие инфекции зачастую связано с началом сексуальной активности. К факторам, способствующим возникновению заболевания, относятся несоблюдение гигиенических норм и использование механических средств контрацепции.
E. Coli в крови
Проникновение бактерий в кровь вызывает бактериемию. Заражение может произойти вследствие инвазии бактерии и попадания в кровоток через стенки кишечника, лимфоидную ткань, дыхательную систему, при удалении зубов и других операций.
При инфекционных заболеваниях возбудитель приникает в кровоток через раны и царапины на коже и внутренний слизистый слой.
Клинические проявления у новорожденных детей выражены:
- нарушением системы терморегуляции;
- психопатологическими расстройствами;
- проявлением дыхательной недостаточности;
- остановкой дыхания во сне;
- рвотой, диареей и желтухой;
- увеличением и изменением тканей печени
- расстройством сна.
У взрослых бактериемия проявляется:
- артериальной гипотензией;
- судорогами;
- нарушением диуреза
Воспаления спинно-мозговой оболочки
Кишечная палочка нередко становится причиной менингита у новорожденных, особенно среди мальчиков с низким весом при рождении.
Симптоматика заболевания проявляется в следующем:
- повышенной сонливостью,
- температурой и рвотой;
- поносом и желтухой;
- остаточными неврологическими нарушениями.
Лечение кишечной палочки
Наличие кишечной палочки подтверждается на основании бактериологического исследования кала, рвоты, слизистого отделяемого. Анализ крови подтверждает или опровергает развитие сепсиса.
По показаниям бактериологического посева составляется индивидуальный план лечения кишечной палочки, в который входит подбор антимикробных средств, антибиотиков и профилактика с учетом вероятного проявления дисбактериоза.
Назначается жидкий раствор регидрона и сорбенты. Соблюдение санитарных правил, предупреждение размножения коли инфекции в пище и воде, убережет многих от проявления эшерихиозов.
Как понять, что у тебя кишечная палочка?
Температура тела может повышаться до 37,5–39 градусов, а в некоторых случаях и выше. Среди симптомов наблюдаются головные боли, мышечная ломота, общая слабость, болевые ощущения, рези в животе, отсутствие аппетита, тошнота, рвота и диарея, при которой возможно появление каловых масс с примесью слизи.
Что нужно принимать от кишечной палочки?
Ципрофлоксацин («Ципринол», «Цифран ОД»). Норфлоксацин («Нормакс», «Норбактин», «Нолицин»). «Офлоксацин».
Чем вылечить кишечную палочку?
Основой терапии кишечных инфекций легкой степени является регидратация, которая заключается в восстановлении утраченной жидкости организма пациента с помощью приема солевых растворов. Также важным элементом лечения является дезинтоксикационная терапия. Для удаления токсинов, образующихся в результате активности возбудителей, применяются сорбенты, эубиотики, ферменты и вяжущие препараты.
Каковы первые признаки кишечной инфекции?
Диарея. Сильный дискомфорт в брюшной области и вздутие живота. Рвота или жалобы на сильную, непроходящую тошноту. Отчетливо слышимые бурление, урчание, газы. Озноб и повышение температуры, слабость. В тяжелых случаях – спутанность сознания.
Профилактика инфекций, вызванных кишечной палочкой
Профилактика инфекций, вызванных кишечной палочкой, играет ключевую роль в снижении заболеваемости и распространенности этой бактерии. Кишечная палочка (Escherichia coli) является частью нормальной микрофлоры кишечника человека и животных, однако некоторые штаммы могут вызывать серьезные инфекции. Чтобы минимизировать риск заражения, необходимо соблюдать ряд простых, но эффективных мер.
1. Соблюдение правил личной гигиены: Регулярное мытье рук с мылом, особенно после посещения туалета, перед едой и после контакта с животными, является одним из самых важных шагов в профилактике. Рекомендуется мыть руки не менее 20 секунд, уделяя внимание всем участкам, включая между пальцами и под ногтями.
2. Правильная обработка и приготовление пищи: Кишечная палочка может находиться в сыром или недостаточно термически обработанном мясе, особенно говядине. Важно готовить мясные продукты до безопасной температуры (не менее 70°C) и избегать перекрестного загрязнения, используя разные доски для сырого мяса и готовых продуктов. Овощи и фрукты также следует тщательно мыть перед употреблением.
3. Безопасное хранение продуктов: Хранение пищи при правильной температуре помогает предотвратить размножение бактерий. Сырые продукты должны храниться отдельно от готовых к употреблению, а холодильник должен поддерживаться при температуре ниже 4°C. Замороженные продукты следует хранить при температуре -18°C или ниже.
4. Внимание к питьевой воде: Вода, используемая для питья и приготовления пищи, должна быть чистой и безопасной. В регионах с низким качеством водоснабжения рекомендуется использовать бутилированную воду или кипятить воду перед употреблением.
5. Образование и информирование: Повышение осведомленности о рисках, связанных с кишечной палочкой, и обучение населения основам безопасного обращения с продуктами питания и личной гигиены могут значительно снизить уровень инфекций. Это особенно важно в школах, детских садах и на предприятиях общественного питания.
6. Вакцинация и контроль за животными: В некоторых случаях вакцинация животных может помочь снизить распространение патогенных штаммов кишечной палочки. Также важно следить за здоровьем домашних животных и проводить регулярные ветеринарные осмотры.
Соблюдение этих простых рекомендаций поможет значительно снизить риск заражения кишечной палочкой и защитить здоровье как индивидуумов, так и общества в целом.
Вопрос-ответ
Какие симптомы указывают на инфекцию кишечной палочкой?
Симптомы инфекции кишечной палочкой могут включать диарею (иногда с кровью), боли в животе, тошноту, рвоту, лихорадку и общее недомогание. Важно отметить, что симптомы могут варьироваться в зависимости от штамма бактерии и состояния здоровья пациента.
Как можно предотвратить заражение кишечной палочкой?
Для предотвращения заражения кишечной палочкой рекомендуется соблюдать правила гигиены: тщательно мыть руки перед едой и после посещения туалета, употреблять только хорошо приготовленную пищу, избегать сырого молока и непроверенных источников воды, а также мыть фрукты и овощи перед употреблением.
Как лечится инфекция, вызванная кишечной палочкой?
Лечение инфекции, вызванной кишечной палочкой, обычно включает поддерживающую терапию, такую как восполнение жидкости и электролитов, особенно при тяжелой диарее. В некоторых случаях могут быть назначены антибиотики, но это зависит от конкретного штамма и состояния пациента. Важно обратиться к врачу для получения рекомендаций по лечению.
Советы
СОВЕТ №1
Обратите внимание на симптомы. Если вы заметили такие признаки, как диарея, боли в животе, тошнота или рвота, особенно после употребления подозрительной пищи, немедленно обратитесь к врачу для диагностики и лечения.
СОВЕТ №2
Соблюдайте правила гигиены. Регулярно мойте руки с мылом, особенно перед едой и после посещения туалета. Это поможет предотвратить заражение кишечной палочкой и другими патогенами.
СОВЕТ №3
Избегайте употребления непроверенных продуктов. Убедитесь, что мясо и молочные продукты хорошо приготовлены и хранятся в правильных условиях. Это снизит риск заражения кишечной палочкой.
СОВЕТ №4
Пейте достаточно жидкости. При диарее и рвоте важно восполнять потерю жидкости и электролитов. Используйте специальные растворы для регидратации или пейте воду, чтобы избежать обезвоживания.